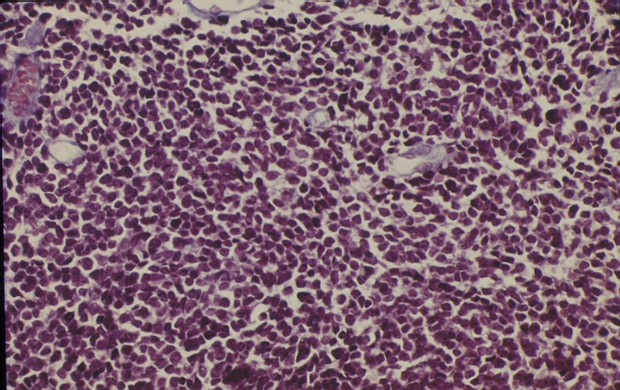

Home » Pineal Gland Histology Pathology Outlines » Pineal Gland Histology Pathology Outlines
Pineal Gland Histology Pathology Outlines
Pathology is one of the most essential fields in usmle step 1.
Pineal gland histology pathology outlines. The system is applicable to all invasive carcinomas. Special subtypes of breast carcinoma lobular tubulolobular tubular papillary mucinous cribriform medullary. Ordinary e mails are welcome.











.jpg)
























